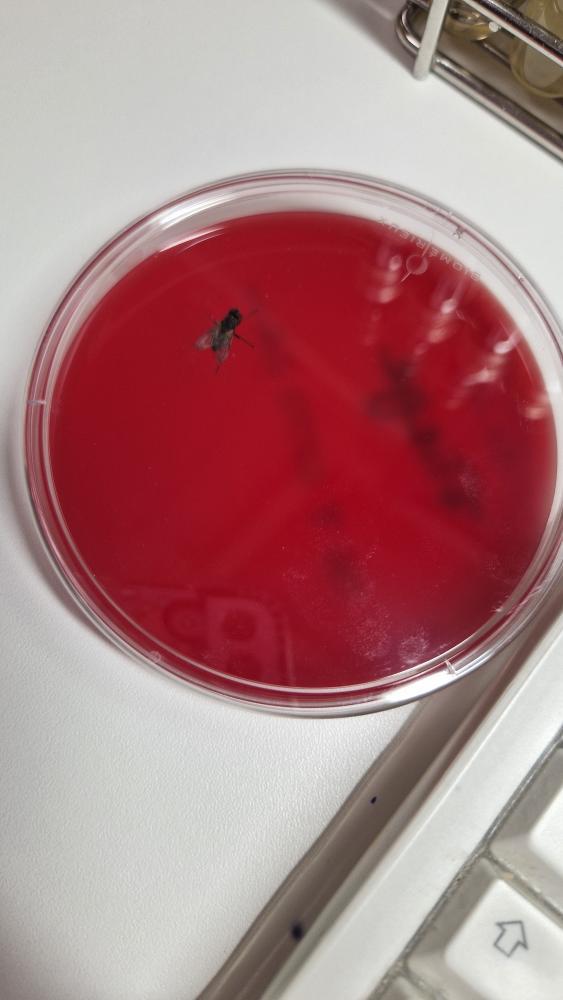
Heliuwum tweet media

dino retweetledi

It’s common sense for everyone but American to not wear your shoes at home
Andra@BioavailableNd
Wearing outside shoes inside the house. According to Dr.Gerba, Microbiologist, there's a 96% chance there's fecal matter on your sole and +400k units of bacteria.
English